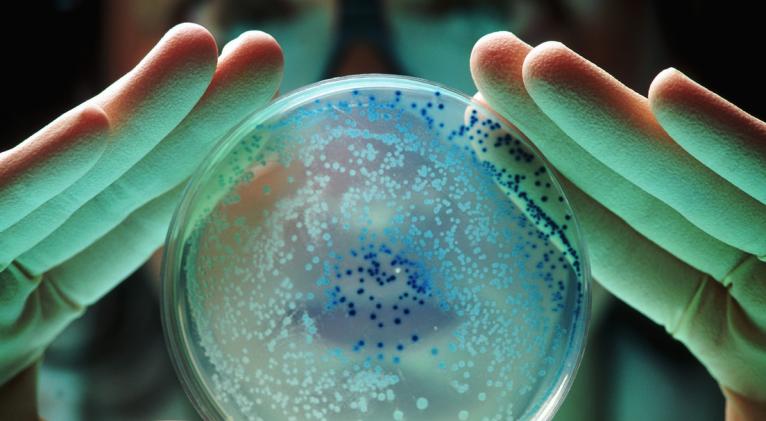
"Pandemia silenciosa"

Un nuevo análisis de la Organización Mundial de la Salud (OMS) advierte sobre una "pandemia silenciosa" causada por bacterias resistentes a los medicamentos debido a la falta de nuevos antibióticos en el mercado y que está matando a miles de personas en todo el mundo.
Según un comunicado previo al Congreso Europeo de Microbiología Clínica y Enfermedades Infecciosas, que se llevará a cabo en línea del 15 al 18 de abril en Copenhague, Dinamarca, solamente 12 antibióticos nuevos ingresaron al mercado entre 2017 y 2021.
Además, señala que solo 27 medicamentos se están probando actualmente contra gérmenes considerados graves por la organización, de los cuales solo seis se consideran lo suficientemente "innovadores" como para ser capaces de superar la resistencia a los antibióticos.
"Solo cuatro de los 27 fármacos antibióticos tienen nuevos mecanismos de acción y la mayoría de ellos no son nuevas clases de fármacos, sino evoluciones de clases de antibióticos existentes", dijo Valeria Gigante, líder de la División de Resistencia a los Antimicrobianos de la OMS.
"Escenario del fin del mundo"
Unas cinco millones de muertes anuales se asocian a la resistencia a los antibióticos, afectando principalmente a las personas pobres, quienes tienen menor acceso a fármacos superiores, que podrían funcionar cuando fallan los de primera línea, según el informe.
Ante esta situación, los expertos médicos instan a fortalecer el desarrollo de medicamentos nuevos y accesibles. Además, advierten de un "escenario del fin del mundo" en el que los antibióticos podrían eventualmente dejar de ser efectivos y un número incalculable de personas podría morir por infecciones que antes eran simples y tratables.
"El rápido aumento de las infecciones multirresistentes en todo el mundo es preocupante. Nos estamos quedando sin tiempo para lanzar nuevos antibióticos al mercado y luchar contra esta amenaza. Sin una acción inmediata, corremos el riesgo de recaer en una era anterior a los antibióticos, cuando las infecciones comunes eran mortales", dijo Gigante.
Investigación mal financiada
Los antimicrobianos en su mayoría son tratamientos a corto plazo, por lo que no representan un panorama tan lucrativo como otros tratamientos para las compañías farmacéuticas.
Además, tienen la misma probabilidad de fallar durante el proceso de investigación y desarrollo que cualquier otro fármaco y, sin embargo, ofrecen un menor retorno de ingresos en comparación con, por ejemplo, los fármacos contra el cáncer y problemas cardiacos. Esto resulta en un proceso de investigación desafiante y mal financiado.
En muchos casos la resistencia a estos fármacos se desarrolla porque las personas no completan su ciclo de antibióticos, fueron recetados incorrectamente o su mal uso, ya que en algunos países se utilizan ampliamente sin receta médica.